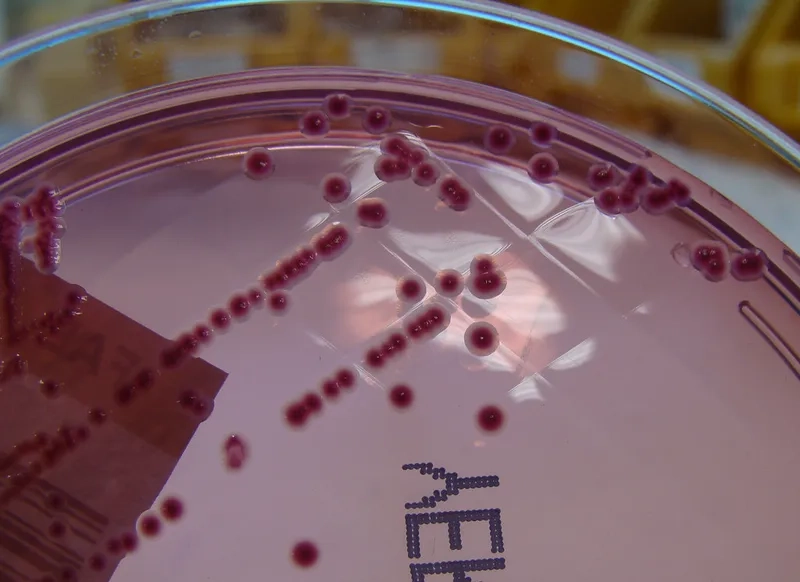
A doctor discussing yersiniosis treatment with a patient

Yersiniosis is a common but often misdiagnosed cause of food poisoning. Understanding its unique symptoms and how it spreads is crucial for protecting your family, especially young children. Don't mistake it for a simple stomach bug.
What are the main causes of Yersiniosis?
- The main cause is the bacterium Yersinia enterocolitica, which is a common source of food poisoning from undercooked pork and contaminated water.
- So, how do you get yersiniosis? Primarily by eating raw or undercooked pork, as pigs are a major natural reservoir for the bacteria.
- The infection can also spread from handling contaminated food or through contact with the feces of an infected person, answering 'is yersiniosis contagious?'

Key symptoms of Yersiniosis to watch for
- Key yersiniosis symptoms include fever, abdominal pain, and bloody diarrhea, typically appearing four to seven days after initial infection.
- In older yersiniosis in children and teens, severe right-sided abdominal pain can mimic appendicitis, a condition known as pseudoappendicitis.
- A potential long-term complication is reactive arthritis yersinia, causing joint pain weeks after the initial intestinal symptoms have resolved.
How can you prevent and treat Yersiniosis effectively?
- The most critical yersiniosis prevention step is practicing proper food safety pork handling, including cooking pork to at least 63°C (145°F).
- Proper handwashing after handling raw meat and before eating is essential to prevent cross-contamination and the spread of the bacteria.
- While most cases resolve on their own, a yersiniosis diagnosis may lead to yersiniosis treatment with antibiotics for yersinia in severe infections.
>>> Details at: Salmonellosis: A Guide to Prevention and Food Safety
Learn about through Yersiniosis medical images

>>> Discover more: Shigellosis: Symptoms, Treatment, and Hand Hygiene Tips
Proper food handling is the best defense against Yersiniosis. If you or your child develop severe abdominal pain after consuming pork, seek medical attention and mention the possible exposure. Early and accurate diagnosis is key.
>>> Related articles: Typhoid Fever: Causes, Symptoms, and Vaccination





